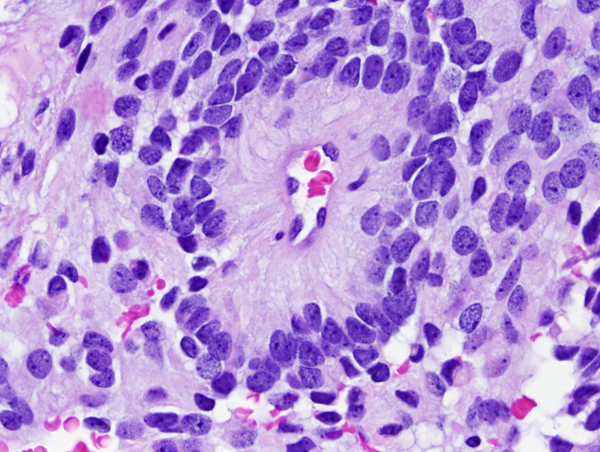

EPENDYMOMA AND CHOROID PLEXUS TUMORS
 Ependymoma of the 4th ventricle |
 Ependymoma of the 4th ventricle and hydrocephalus. |
 Ependymoma of the 4th ventricle |
 Ependymoma of the 4th ventricle |
Ependymomas are predominantly tumors of children and adolescents. They arise most frequently in the fourth ventricle and cause hydrocephalus by blocking CSF flow. However, they may occur anywhere in relation to the ventricular system or central canal of the spinal cord and are the most common primary intra-axial tumors in the spinal cord and filum terminale. Ependymomas are well demarcated from the surrounding brain and grow in an exophytic fashion, protruding into and out of the fourth ventricle. Spinal ependymomas are circumscribed intra-axial masses. Some supratentorial ependymomas are exraventricular and may be cystic.
Microscopically, the tumor cells resemble normal ependymal cells and are arranged in perivascular pseudorosettes (tumor cell nuclei located at some distance from a central vessel with delicate processes radiating toward the vessel wall), tubular structures like the central canal of the spinal cord, and papillary formations. Ependymoma has distinctive ultrastructural features, including cilia, microvilli, and desmosomes. Ependymomas are graded as grade II or III according to the WHO system. Most are low-grade (WHO grade II). Some have increased cellular density, mitoses, necrosis, and microvascular proliferation while retaining the typical ependymoma tissue pattern (anaplastic ependymoma, WHO grade III).
It is now evident that grade II and grade III ependymoma is not a single disease but includes several biological entities, some of which have distinct molecular signatures. Supratentorial (ST) and posterior fossa (PF) ependymomas (EPN) fall under four molecular subgroups:
ST-EPN-RELA: The majority of ST EPN in children and adults, characterized by fusion of C11orf95 and RELA genes.
ST-EPN-YAP1: Predominantly childhood ependymomas with favorable prognosis, characterized by fusions of YAP1.
PF-EPN-A: Laterally located 4th ventricle EPNs in infants and young children with increased gene methylation, which are difficult to resect and have high recurrence rates.
PF-EPN- B: 4th ventricle EPNs in adolescents and young adults with chromosomal gains and losses, associated with good prognosis.
The molecular subgroup and clinical parameters such as patient age and completeness of resection are more important for prognosis than WHO grade.
There are 2 WHO grade I special variants of ependymoma: Myxopapillary ependymoma is characterized by papillary formations with a mucinous core and arises most commonly in the lumbosacral spinal cord and sometimes in the soft tissues of the lumbosacral region. Subependymoma, is most commonly an intraventricular (4th ventricle) tumor of adults. It is a firm, nodular tumor, consisting of uniform cells in a fibrillary stroma with cystic degeneration.
CHOROID PLEXUS TUMORS
Choroid plexus tumors affect mostly children and young adults. They are a continuum which includes choroid plexus papilloma-CPP (WHO grade I), atypical CPP (WHO grade II) and choroid plexus carcinoma-CPC (WHO grade III). CPC is most common in very young children and is seen in older patients. In children, CPP and CPC arise in both, lateral and fourth ventricles. In adults, CPP is more frequent in the fourth ventricle and sometimes arises in the cerebellopontine angle. CPP is seen in the Aicardi syndrome, an X-linked syndrome in females, characterized by agenesis of the corpus callosum, chorioretinal lacunae, and infantile spasms. CPC occurs in the rhabdoid tumor predisposition syndrome, caused by germline mutations of the INI1 gene. Choroid plexus tumors cause hydrocephalus and increased intracranial pressure by blocking CSF pathways and by oversecreting CSF. CPC can also seed the subarachnoid space. Both, CPP and CPC have a papillary basic structure. In CPP the papillae are covered by a single layer of benign epithelial cells, similar to normal choroid plexus. In CPC the tumor cells are multilayered, atypical, and mitotic, and the papillary structure may be effaced such that the tumor appears solid.
Updated: July, 2017